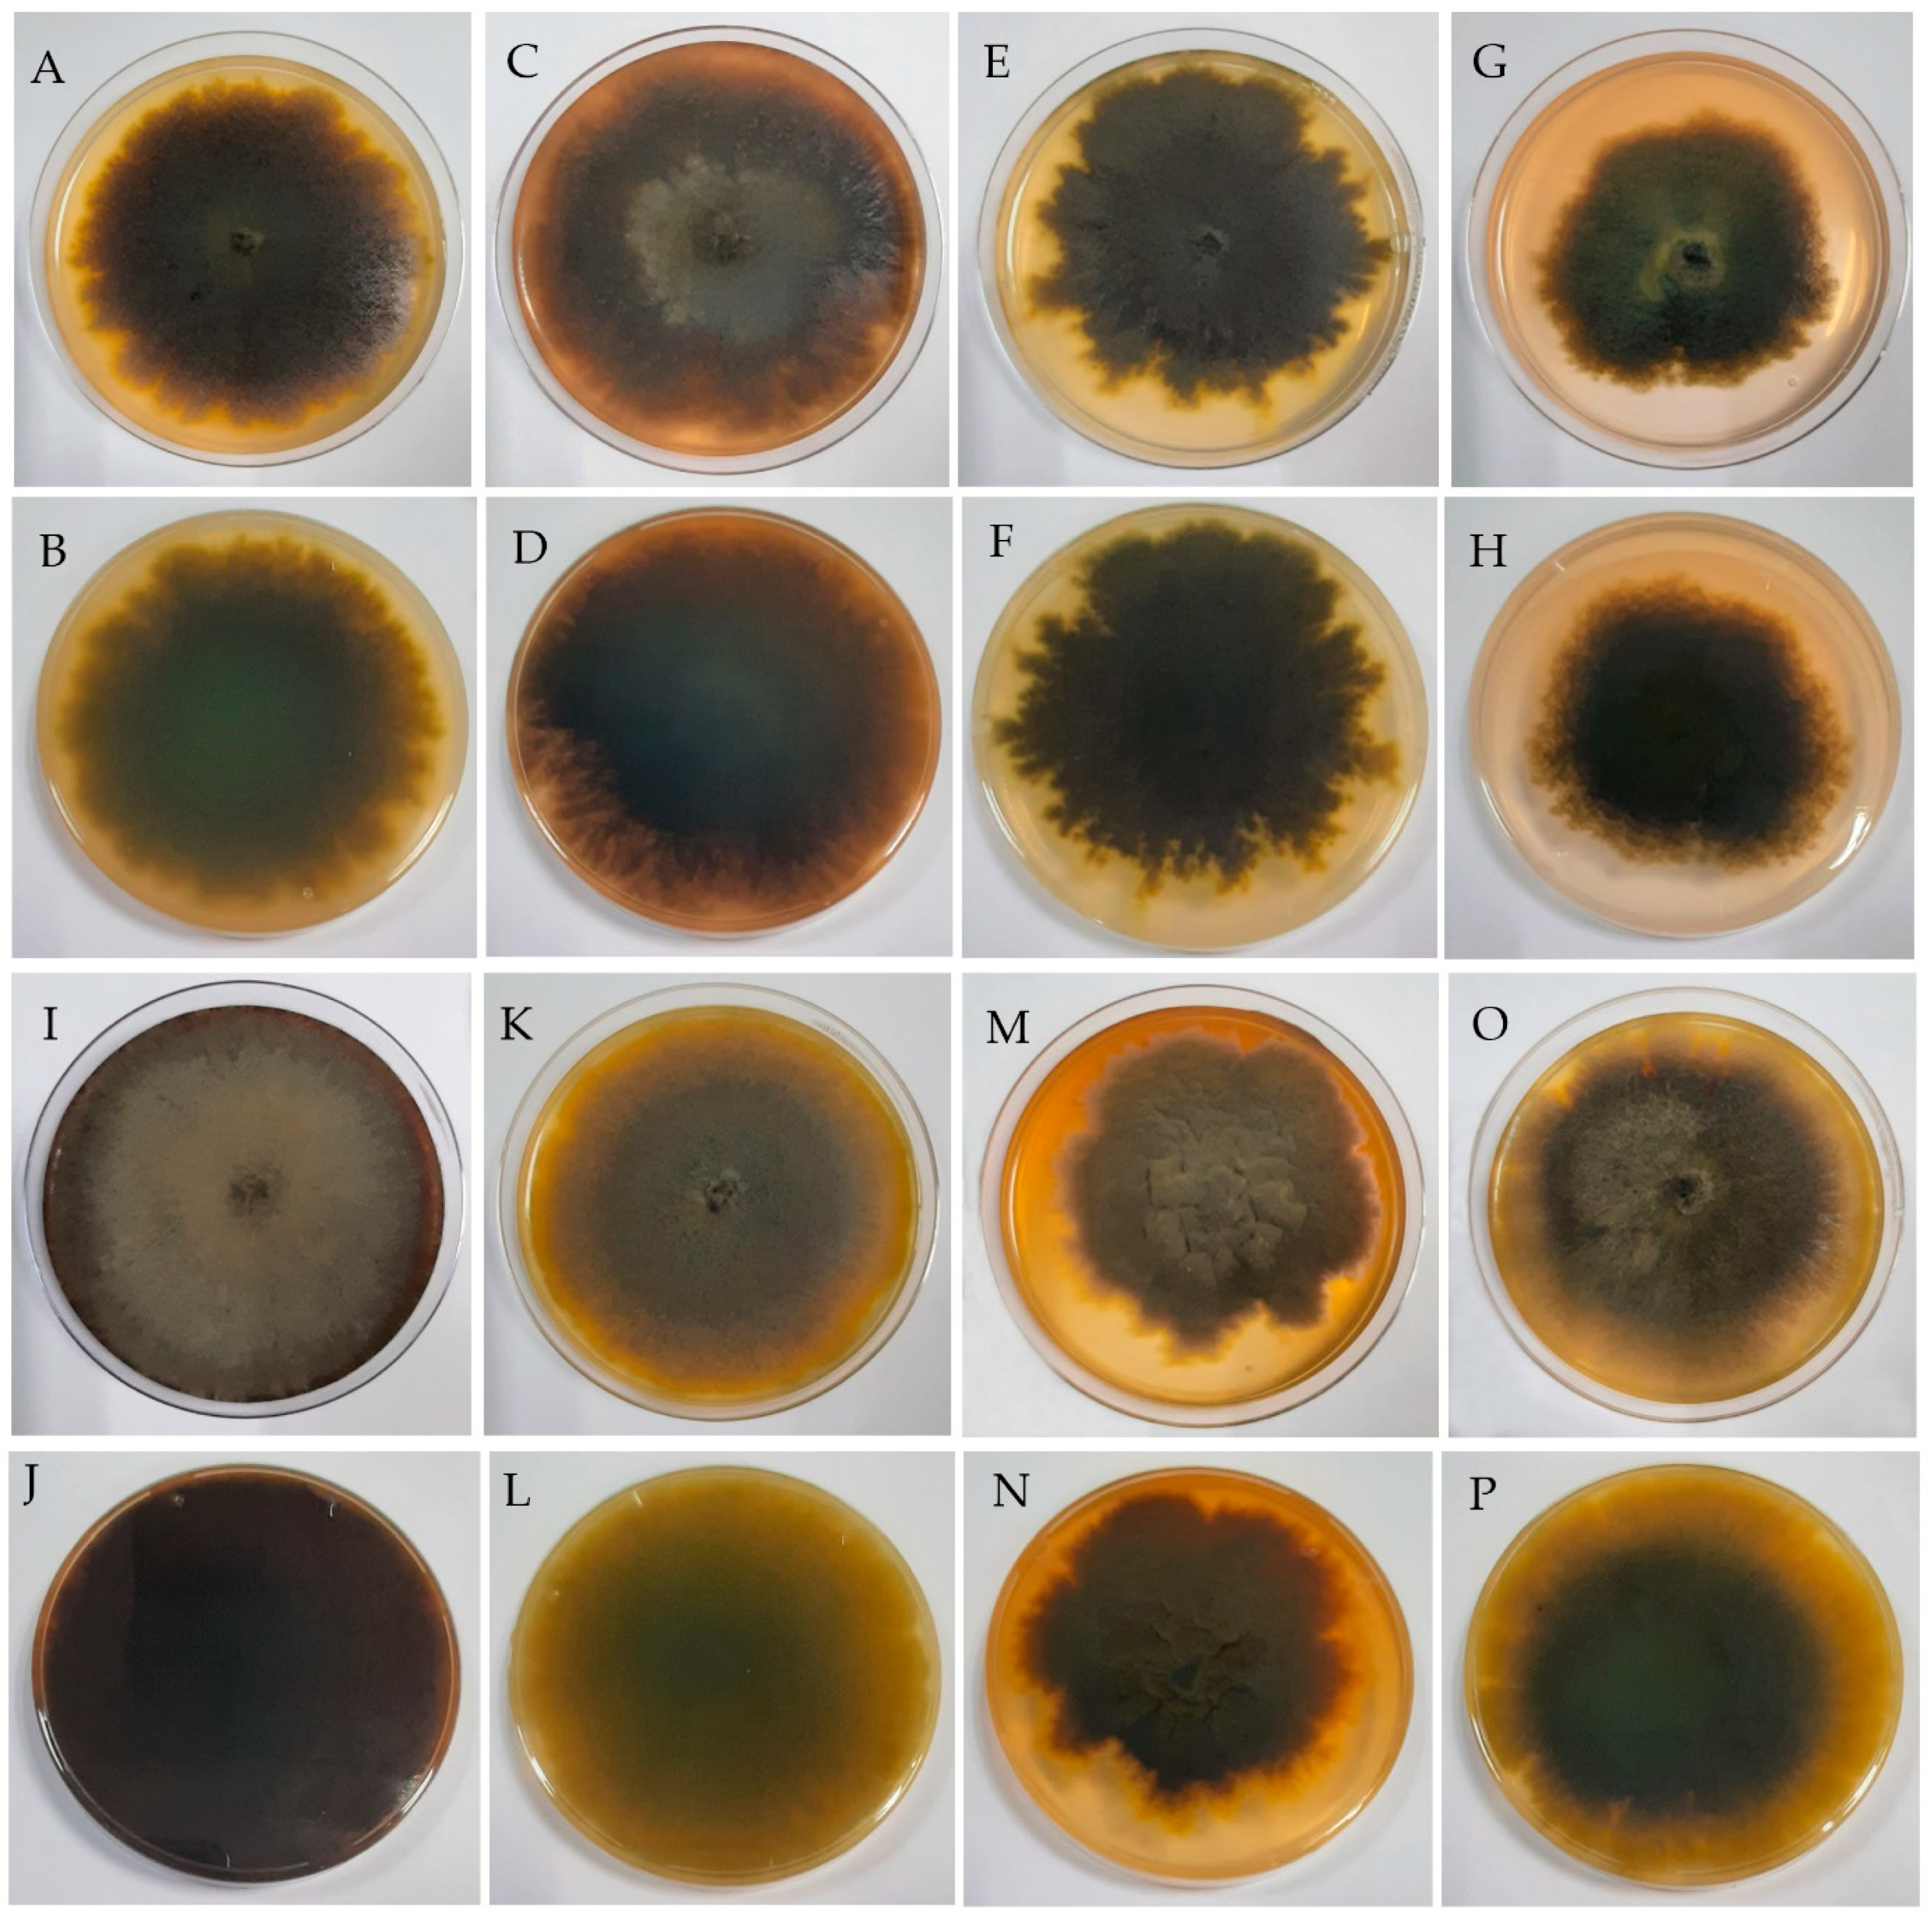
Jof 10 00791 g002 Jof 10 00791 g002

Discovery of Alanomyces manoharacharyi: A Novel Fungus Identified Using Genome Sequencing and Metabolomic Analysis
Abstract
1. Introduction
2. Materials and Methods
2.1. Collection, Isolation, and Morphological Characterization
2.2. DNA Extraction, PCR Amplification, and DNA Sequencing
2.3. Phylogenetic Analysis
2.4. Identification of the Isolate by MALDI-TOF Mass Spectrometry
2.5. High Molecular Weight DNA Extraction for Whole-Genome Sequencing
2.6. Library Preparation and Sequencing
2.7. Genome Assembly
2.8. Genome Prediction and Annotation
2.9. Analysis of Secondary Metabolite Biosynthetic Gene Clusters
2.10. Comparative Genomics and Phylogenetic Analysis
2.11. Characterization of Transcripts
2.12. Fermentation and Extraction of Metabolites of the Isolate for Metabolomic Study
2.13. Sample Preparation for Untargeted Metabolomics
2.14. UHPLC and MS Parameters
2.15. Data Analysis Pipeline for Metabolomics
3. Results
3.1. Phylogenetic Analysis
3.2. Taxonomy
3.3. Identification of the Isolate by MALDI-TOF Mass Spectrometry
3.4. Genome Sequencing and Assembly of Alanomyces manoharacharyi NFCCI 5738
3.5. Genome Sequence Annotation of Alanomyces manoharacharyi NFCCI 5738
3.6. Genome Sequence Annotation of Alanomyces manoharacharyi NFCCI 5738 for Carbohydrate Genes
3.7. Genome Sequence Annotation of Alanomyces manoharacharyi NFCCI 5738 for Pathogen–Host Interactions
3.8. AntiSMASH Analysis of Alanomyces manoharacharyi NFCCI 5738
3.9. Comparative Phylogenetics and Genomics
3.9.1. Average Nucleotide Identity
3.9.2. Phylogeny Based on Orthologous Proteins
3.9.3. Phylogeny Based on Single Nucleotide Polymorphisms (SNPs)
3.10. Characterization of Transcripts
3.11. Metabolites from Alanomyces manoharacharyi
4. Conclusions
Supplementary Materials
Author Contributions
Funding
Institutional Review Board Statement
Informed Consent Statement
Data Availability Statement
Acknowledgments
Conflicts of Interest
References
- Nthuku, B.M.; Kahariri, E.W.; Kinyua, J.K.; Nyaboga, E.N. Fungal endophytes of Moringa (Moringa oleifera L.), Neem (Azadirachta indica) and Lavender (Lavandula angustifolia) and their biological control of Fusarium wilt of Banana. Microbiol. Res. 2023, 14, 2113–2132. [Google Scholar] [CrossRef]
- Verma, V.C.; Gond, S.K.; Kumar, A.; Kharwar, R.N.; Strobel, G. The endophytic mycoflora of bark, leaf, and stem tissues of Azadirachta indica A. Juss (neem) from Varanasi (India). Microb. Ecol. 2007, 54, 119–125. [Google Scholar] [PubMed]
- Sharma, D.; Pramanik, A.; Agrawal, P.K. Evaluation of bioactive secondary metabolites from endophytic fungus Pestalotiopsis neglecta BAB-5510 isolated from leaves of Cupressus torulosa D. Don. 3 Biotech 2016, 6, 210. [Google Scholar] [CrossRef] [PubMed]
- Umurhurhu, J.O.; Okezie, U.M.; Ngwoke, K.G. Evaluation of the antimicrobial and antiviral potentials of extracts of endophytic fungi from Azadirachta indica. GSC Biol. Pharm. Sci. 2023, 23, 061–066. [Google Scholar] [CrossRef]
- Fulzele, V.A.; Qureshi, A.; Fulzele, A.A. Evaluation of antifungal potential of endophytic fungus Preussia isabellae isolated from Azadirachta indica. Int. J. Res. Biosci. Agric. 2018, 3, 150–153. [Google Scholar]
- Chukwuemerie, O.L.; Ugochukwu, S.B.; Iloh, E.S.; Onwuzuluigbo, C.C.; Onyegbule, F.A.; Okoye, F.B.C. Toxicological analysis and antimalarial potentials of secondary metabolites of Curvularia lunata, an endophyte obtained from the leaves of Azadirachta indica. Afr. J. Pharm. Sci. 2022, 2, 80–91. [Google Scholar] [CrossRef]
- Li, G.H.; Yu, Z.F.; Li, X.; Wang, X.B.; Zheng, L.J.; Zhang, K.Q. Nematicidal metabolites produced by the endophytic fungus Geotrichum sp. AL4. Chem. Biodivers. 2007, 4, 1520–1524. [Google Scholar]
- Slippers, B.; Boissin, E.; Phillips, A.J.; Groenewald, J.Z.; Lombard, L.; Wingfield, M.J.; Postma, A.; Burgess, T.; Crous, P.W. Phylogenetic lineages in the Botryosphaeriales: A systematic and evolutionary framework. Stud. Mycol. 2013, 76, 31–49. [Google Scholar] [CrossRef]
- Agaricus bonaerensis Speg. Anal. Soc. Cient. Argent. 1880, 9, 278.
- Sharma, R.; Kulkarni, G.; Sonawane, M.S. Alanomyces, a new genus of Aplosporellaceae based on four loci phylogeny. Phytotaxa 2017, 297, 168–175. [Google Scholar] [CrossRef]
- Damm, U.; Fourie, P.H.; Crous, P.W. Aplosporella prunicola, a novel species of anamorphic Botryosphaeriaceae. Fungal Divers. 2007, 27, 35–43. [Google Scholar]
- Dou, Z.P.; Lu, M.; Wu, J.R.; He, W.; Zhang, Y. A new species and interesting records of Aplosporella from China. Sydowia 2017, 69, 1–7. [Google Scholar]
- Dobranic, J.K.; Johnson, J.A.; Alikhan, Q.R. Isolation of endophytic fungi from eastern larch (Larix laricina) leaves from New Brunswick, Canada. Can. J. Microbiol. 1995, 41, 194–198. [Google Scholar] [CrossRef]
- Bills, G.F.; Polishook, J.D. Recovery of endophytic fungi from Chamaecyparis thyoides. Sydowia 1992, 44, 1–12. [Google Scholar]
- Kornerup, A.; Wanscher, J.H. Metheun’s Handbook of Colours, 3rd ed.; Metheun and Co. Ltd.: London, UK, 1978. [Google Scholar]
- Aamir, S.; Sutar, S.; Singh, S.K.; Baghela, A. A rapid and efficient method of fungal genomic DNA extraction, suitable for PCR based molecular methods. Plant Pathol. Quar. J. Fungal. Biolog. 2015, 5, 74–81. [Google Scholar] [CrossRef]
- White, T.J.; Bruns, T.; Lee, S.; Taylor, J.W. Amplification and direct sequencing of fungal ribosomal RNA genes for phylogenetics. In PCR Protocols: A Guide to Methods and Applications, 1st ed.; Innis, M.A., Gelfand, D.H., Sninsky, J.J., White, T.J., Eds.; Academic Press: Cambridge, MA, USA, 1990; pp. 315–322. [Google Scholar]
- Vilgalys, R.; Sun, B.L. Ancient and recent patterns of geographic speciation in the oyster mushroom Pleurotus revealed by phylogenetic analysis of ribosomal DNA-sequences. Proc. Natl. Acad. Sci. USA 1994, 91, 7832. [Google Scholar] [CrossRef]
- Vilgalys, R.; Hester, M. Rapid genetic identification and mapping of enzymatically amplified ribosomal DNA from several Cryptococcus species. J. Bacteriol. 1990, 172, 4238–4246. [Google Scholar] [CrossRef]
- Katoh, K.; Rozewicki, J.; Yamada, K.D. MAFFT online service: Multiple sequence alignment, interactive sequence choice and visualization. Brief. Bioinform. 2019, 20, 1160–1166. [Google Scholar] [CrossRef]
- Larsson, A. AliView: A fast and lightweight alignment viewer and editor for large data sets. Bioinformatics 2014, 30, 3276–3278. [Google Scholar] [CrossRef]
- Darriba, D.; Taboada, G.L.; Doallo, R.; Posada, D. jModelTest 2: More models, new heuristics and parallel computing. Nat. Methods 2012, 9, 772. [Google Scholar] [CrossRef]
- Nguyen, L.; Schmidt, H.A.; von Haeseler, A.; Minh, B.Q. IQ-TREE: A fast and effective stochastic algorithm for estimating maximum-likelihood phylogenies. Mol. Biol. Evol. 2015, 32, 268–274. [Google Scholar] [CrossRef] [PubMed]
- Ewels, P.; Magnusson, M.; Lundin, S.; Käller, M. MultiQC: Summarize analysis results for multiple tools and samples in a single report. Bioinformatics 2016, 32, 3047–3048. [Google Scholar] [CrossRef] [PubMed]
- Chen, S.; Zhou, Y.; Chen, Y.; Gu, J. Fastp: An ultra-fast all-in-one FASTQ preprocessor. Bioinformatics 2018, 34, i884–i890. [Google Scholar] [CrossRef]
- Li, D.; Liu, C.M.; Luo, R.; Sadakane, K.; Lam, T.W. MEGAHIT: An ultra-fast single-node solution for large and complex metagenomics assembly via succinct de Bruijn graph. Bioinformatics 2015, 31, 1674–1676. [Google Scholar] [CrossRef]
- Bankevich, A.; Nurk, S.; Antipov, D.; Gurevich, A.A.; Dvorkin, M.; Kulikov, A.S.; Lesin, V.M.; Nikolenko, S.I.; Pham, S.; Prjibelski, A.D.; et al. SPAdes: A new genome assembly algorithm and its applications to single-cell sequencing. J. Comput. Biol. 2012, 19, 455–477. [Google Scholar] [CrossRef]
- Zimin, A.V.; Marçais, G.; Puiu, D.; Roberts, M.; Salzberg, S.L.; Yorke, J.A. The MaSuRCA genome assembler. Bioinformatics 2013, 29, 2669–2677. [Google Scholar] [CrossRef] [PubMed]
- Gurevich, A.; Saveliev, V.; Vyahhi, N.; Tesler, G. QUAST: Quality assessment tool for genome assemblies. Bioinformatics 2013, 29, 1072–1075. [Google Scholar] [CrossRef] [PubMed]
- Langmead, B.; Salzberg, S. Fast gapped-read alignment with Bowtie 2. Nat. Methods 2012, 9, 357–359. [Google Scholar] [CrossRef] [PubMed]
- Waterhouse, R.M.; Seppey, M.; Simão, F.A.; Manni, M.; Ioannidis, P.; Klioutchnikov, G.; Kriventseva, E.V.; Zdobnov, E.M. BUSCO Applications from Quality Assessments to Gene Prediction and Phylogenomics. Mol. Bio. Evol. 2018, 35, 543–548. [Google Scholar] [CrossRef]
- Krzywinski, M.; Schein, J.; Birol, I.; Connors, J.; Gascoyne, R.; Horsman, D.; Jones, S.J.; Marra, M.A. Circos: An information aesthetic for comparative genomics. Genome Res. 2009, 19, 1639–1645. [Google Scholar] [CrossRef]
- Stanke, M.; Waack, S. Gene prediction with a hidden Markov model and a new intron submodel. Bioinformatics 2003, 19, 215–225. [Google Scholar] [CrossRef] [PubMed]
- Stanke, M.; Diekhans, M.; Baertsch, R.; Haussler, D. Using native and syntenically mapped cDNA alignments to improve gene finding. Bioinformatics 2008, 24, 637–644. [Google Scholar] [CrossRef] [PubMed]
- Keller, O.; Kollmar, M.; Stanke, M.; Waack, S. A novel hybrid gene prediction method employing protein multiple sequence alignments. Bioinformatics 2011, 27, 757–763. [Google Scholar] [CrossRef]
- Keilwagen, J.; Hartung, F.; Grau, J. GeMoMa: Homology-based gene prediction utilizing intron position conservation and RNA-seq data. Methods Mol. Biol. 2019, 1962, 161–177. [Google Scholar]
- Blin, K.; Shaw, S.; Augustijn, H.E.; Reitz, Z.L.; Biermann, F.; Alanjary, M.; Fetter, A.; Terlouw, B.R.; Metcalf, W.W.; Helfrich, E.J.N.; et al. AntiSMASH 7.0: New and improved predictions for detection, regulation, chemical structures and visualisation. Nucleic Acids Res. 2023, 51, W46–W50. [Google Scholar] [CrossRef]
- Emms, D.M.; Kelly, S. OrthoFinder: Phylogenetic orthology inference for comparative genomics. Genome Biol. 2019, 20, 238. [Google Scholar] [CrossRef] [PubMed]
- Letunic, I.; Bork, P. Interactive Tree of Life (iTOL) v6: Recent updates to the phylogenetic tree display and annotation tool. Nucleic Acids Res. 2024, 52, gkae268. [Google Scholar] [CrossRef]
- Pritchard, L.; Glover, R.H.; Humphris, S.; Elphinstone, J.G.; Toth, I.K. Genomics and taxonomy in diagnostics for food security: Softrotting enterobacterial plant pathogens. Anal. Methods 2016, 8, 12–24. [Google Scholar] [CrossRef]
- Laing, C.; Buchanan, C.; Taboada, E.N.; Zhang, Y.; Kropinski, A.; Villegas, A.; Thomas, J.E.; Gannon, V.P. Pan-genome sequence analysis using Panseq: An online tool for the rapid analysis of core and accessory genomic regions. BMC Bioinform. 2010, 11, 461. [Google Scholar] [CrossRef]
- Armenteros, J.J.; Tsirigos, K.D.; Sønderby, C.K.; Petersen, T.N.; Winther, O.; Brunak, S.; von Heijne, G.; Nielsen, H. SignalP 5.0 improves signal peptide predictions using deep neural networks. Nat. Biotechnol. 2019, 37, 420–423. [Google Scholar] [CrossRef]
- Armenteros, J.J.; Salvatore, M.; Emanuelsson, O.; Winther, O.; von Heijne, G.; Elofsson, A.; Nielsen, H. Detecting sequence signals in targeting peptides using deep learning. Life Sci. Alliance 2019, 2, e201900429. [Google Scholar] [CrossRef] [PubMed]
- Krogh, A.; Larsson, B.; Von Heijne, G.; Sonnhammer, E.L. Predicting transmembrane protein topology with a hidden Markov model: Application to complete genomes. J. Mol. Biol. 2001, 305, 567–580. [Google Scholar] [CrossRef] [PubMed]
- Natale, D.A.; Shankavaram, U.T.; Galperin, M.Y.; Wolf, Y.I.; Aravind, L.; Koonin, E.V. Towards understanding the first genome sequence of a crenarchaeon by genome annotation using clusters of orthologous groups of proteins (COGs). Genome Biol. 2000, 1, RESEARCH0009. [Google Scholar] [CrossRef] [PubMed]
- Yamada, Y.; Hirakawa, H.; Hori, K.; Minakuchi, Y.; Toyoda, A.; Shitan, N.; Sato, F. Comparative analysis using the draft genome sequence of California poppy (Eschscholzia californica) for exploring the candidate genes involved in benzylisoquinoline alkaloid biosynthesis. Biosci. Biotechnol. Biochem. 2021, 85, 851–859. [Google Scholar] [CrossRef]
- Huntley, R.P.; Harris, M.A.; Alam-Faruque, Y.; Blake, J.A.; Carbon, S.; Dietze, H.; Dimmer, E.C.; Foulger, R.E.; Hill, D.P.; Khodiyar, V.K.; et al. A method for increasing expressivity of Gene Ontology annotations using a compositional approach. BMC Bioinform. 2014, 15, 155. [Google Scholar] [CrossRef]
- Garron, M.L.; Henrissat, B. The continuing expansion of CAZymes and their families. Curr. Opin. Chem. Biol. 2019, 53, 82–87. [Google Scholar] [CrossRef]
- Liu, Y.; Xu, M.; Tang, Y.; Shao, Y.; Wang, H.; Zhang, H. Genome Features and AntiSMASH Analysis of an Endophytic Strain Fusarium sp. R1. Metabolites 2022, 12, 521. [Google Scholar] [CrossRef]
- Urban, M.; Cuzick, A.; Seager, J.; Wood, V.; Rutherford, K.; Venkatesh, S.Y.; Sahu, J.; Iyer, S.V.; Khamari, L.; De Silva, N.; et al. PHI-base in 2022: A multi-species phenotype database for pathogen-host interactions. Nucleic Acids Res. 2022, 50, D837–D847. [Google Scholar] [CrossRef]
- Pernas, L. Cellular metabolism in the defense against microbes. J. Cell Sci. 2021, 134, jcs252023. [Google Scholar] [CrossRef]
- Zhang, A.; Lu, P.; Dahl-Roshak, A.M.; Paress, P.S.; Kennedy, S.; Tkacz, J.S.; An, Z. Efficient disruption of a polyketide synthase gene (pks1) required for melanin synthesis through Agrobacterium-mediated transformation of Glarea lozoyensis. Mol. Genet. Genom. MGG 2003, 268, 645–655. [Google Scholar] [CrossRef]
- Yan, Y.; Liu, Q.; Zang, X.; Yuan, S.; Bat-Erdene, U.; Nguyen, C.; Gan, J.; Zhou, J.; Jacobsen, S.E.; Tang, Y. Resistance-gene-directed discovery of a natural-product herbicide with a new mode of action. Nature 2018, 559, 415–418. [Google Scholar] [CrossRef]
- Chooi, Y.H.; Krill, C.; Barrow, R.A.; Chen, S.; Trengove, R.; Oliver, R.P.; Solomon, P.S. An in planta-expressed polyketide synthase produces (R)-mellein in the wheat pathogen Parastagonospora nodorum. Appl. Environ. Microbiol. 2015, 81, 177–186. [Google Scholar] [CrossRef] [PubMed]
- Mitaka, Y.; Mori, N.; Matsuura, K. A termite fungistatic compound, mellein, inhibits entomopathogenic fungi but not egg-mimicking termite ball fungi. Appl. Entomol. Zool. 2019, 54, 39–46. [Google Scholar] [CrossRef]
- Mattoon, E.R.; Cordero, R.J.B.; Casadevall, A. Fungal Melanins and Applications in Healthcare, Bioremediation and Industry. J. Fungi 2021, 7, 488. [Google Scholar] [CrossRef] [PubMed]
- Shimada, A.; Kusano, M.; Takeuchi, S.; Fujioka, S.; Inokuchi, T.; Kimura, Y. Aspterric acid and 6-hydroxymellein, inhibitors of pollen development in Arabidopsis thaliana, produced by Aspergillus terreus. Z. Naturforsch. C. J. Biosci. 2002, 57, 459–464. [Google Scholar] [CrossRef] [PubMed]
- Patel, D.P.; Swink, S.M.; Castelo-Soccio, L. A Review of the Use of Biotin for Hair Loss. Skin Appendage Disord. 2017, 3, 166–169. [Google Scholar] [CrossRef]
- Jiang, H.; Li, Y.; Xiang, X.; Tang, Z.; Liu, K.; Su, Q.; Zhang, X.; Li, L. Chaetocin: A review of its anticancer potentials and mechanisms. Eur. J. Pharmacol. 2021, 910, 174459. [Google Scholar] [CrossRef]
- Saleem, M.; Tousif, M.I.; Riaz, N.; Ahmed, I.; Schulz, B.; Ashraf, M.; Nasar, R.; Pescitelli, G.; Hussain, H.; Jabbar, A.; et al. Cryptosporioptide: A bioactive polyketide produced by an endophytic fungus Cryptosporiopsis sp. Phytochemistry 2013, 93, 199–202. [Google Scholar] [CrossRef]
- Bacha, S.A.S.; Li, Y.; Nie, J.; Xu, G.; Han, L.; Farooq, S. Comprehensive review on patulin and Alternaria toxins in fruit and derived products. Front. Plant Sci. 2023, 14, 1139757. [Google Scholar] [CrossRef]
- Teakel, S.L.; Fairman, J.W.; Muruthi, M.M.; Abendroth, J.; Dranow, D.M.; Lorimer, D.D.; Myler, P.J.; Edwards, T.E.; Forwood, J.K. Structural characterization of aspartate-semialdehyde dehydrogenase from Pseudomonas aeruginosa and Neisseria gonorrhoeae. Sci. Rep. 2022, 12, 14010. [Google Scholar] [CrossRef]
- Neuzil, E.; Ravaine, S.; Cousse, H. La N-acétyl-DL-leucine, médicament symptomatique de vertigineux. Bull. Soc. Pharm. Bordx. 2002, 141, 15–38. [Google Scholar]
- Sarkar, C.; Lipinski, M.M. N-acetyl-L-leucine: A promising treatment option for traumatic brain injury. Neural Regen Res. 2022, 17, 1957–1958. [Google Scholar] [CrossRef] [PubMed]
- Liu, Y.; Marmann, A.; Abdel-Aziz, M.S.; Wang, C.Y.; Müller, W.E.; Lin, W.H.; Mándi, A.; Kurtán, T.; Daletos, G.; Proksch, P. Tetrahydroanthraquinone derivatives from the endophytic fungus Stemphylium globuliferum. Eur. J. Org. Chem. 2015, 12, 2646–2653. [Google Scholar] [CrossRef]
- Ikeda, H.; Tsuji, E.; Matsubara, T.; Yukawa, M.; Fujisawa, M.; Yukawa, E.; Aki, H. Incompatibility between propericiazine oral solution and tea-based drink. Chem. Pharm. Bull. 2012, 60, 1207–1211. [Google Scholar] [CrossRef]
- Tan, L.T.; Phyo, M.Y. Marine Cyanobacteria: A Source of Lead Compounds and their Clinically-Relevant Molecular Targets. Molecules 2020, 25, 2197. [Google Scholar] [CrossRef]
- Du, L.; Zhu, T.; Fang, Y.; Liu, H.; Gu, Q.; Zhu, W. Aspergiolide A, a novel anthraquinone derivative with naphtho[1,2,3-de]chromene-2,7-dione skeleton isolated from a marine-derived fungus Aspergillus glaucus. Tetrahedron 2007, 63, 1085–1088. [Google Scholar] [CrossRef]
- Sun, X.; Zhou, X.; Cai, M.; Tao, K.; Zhang, Y. Identified biosynthetic pathway of aspergiolide A and a novel strategy to increase its production in a marine-derived fungus Aspergillus glaucus by feeding of biosynthetic precursors and inhibitors simultaneously. Bioresour. Technol. 2009, 100, 4244–4251. [Google Scholar] [CrossRef]
- Tanumihardjo, S.A. Carotenoids: Health Effects. In Encyclopedia of Human Nutrition, 3rd ed.; Caballero, B., Ed.; Academic Press: Cambridge, MA, USA, 2013; pp. 292–297. [Google Scholar]
- Venkataramana, H.S.; Puttaswamy, N.; Kodimule, S. Potential benefits of oral administration of Amorphophallus Konjac glycosylceramides on skin health-a randomized clinical study. BMC Complement. Med. Ther. 2020, 20, 26. [Google Scholar] [CrossRef]
- Trefely, S.; Doan, M.T.; Snyder, N.W. Chapter One-Crosstalk between cellular metabolism and histone acetylation. In Methods in Enzymology, 1st ed.; Garcia, B.A., Ed.; Academic Press: Cambridge, MA, USA, 2019; Volume 626, pp. 1–21. [Google Scholar]
- Beenker, W.A.G.; Hoeksma, J.; den Hertog, J. Gregatins, a Group of Related Fungal Secondary Metabolites, Inhibit Aspects of Quorum Sensing in Gram-Negative Bacteria. Front. Microbiol. 2022, 13, 934235. [Google Scholar] [CrossRef]
- Marino, S.D.; Festa, C.; D’Auria, M.V.; Bourguet-Kondracki, M.; Petek, S.; Debitus, C.; Andrés, R.M.; Terencio, M.C.; Payá, M.; Zampella, A. Coscinolactams A and B: New nitrogen-containing sesterterpenoids from the marine sponge Coscinoderma mathewsi exerting anti-inflammatory properties. Tetrahedron 2009, 65, 2905–2909. [Google Scholar] [CrossRef]
- Kim, M.C.; Cullum, R.; Machado, H.; Smith, A.J.; Yang, I.; Rodvold, J.J.; Fenical, W. Photopiperazines A-D, Photosensitive Interconverting Diketopiperazines with Significant and Selective Activity against U87 Glioblastoma Cells, from a Rare, Marine-Derived Actinomycete of the Family Streptomycetaceae. J. Nat. Prod. 2019, 82, 2262–2267. [Google Scholar] [CrossRef] [PubMed]
- Hudson, G.A.; Zhang, Z.; Tietz, J.I.; Mitchell, D.A.; Donk, W.A. In Vitro Biosynthesis of the Core Scaffold of the Thiopeptide Thiomuracin. J. Am. Chem. Soc. 2015, 137, 16012–16015. [Google Scholar] [CrossRef]
- Kubomura, D.; Ueno, T.; Yamada, M.; Tomonaga, A.; Nagaoka, I. Effect of N-acetylglucosamine administration on cartilage metabolism and safety in healthy subjects without symptoms of arthritis: A case report. Exp. Ther. Med. 2017, 13, 1614–1621. [Google Scholar] [CrossRef] [PubMed][Green Version]
- Nagai, H.; Sato, S.; Iida, K.; Hayashi, K.; Kawaguchi, M.; Uchida, H.; Satake, M. Oscillatoxin I: A New Aplysiatoxin Derivative, from a Marine Cyanobacterium. Toxins 2019, 11, 366. [Google Scholar] [CrossRef] [PubMed]
- Ghadimi, H.; Ghani, S.A.; Amiri, I.S. Chapter 1–Introduction. In Electrochemistry of Dihydroxybenzene Compounds, 1st ed.; Ghadimi, H., Ghani, S., Amiri, I.S., Eds.; Elsevier: Amsterdam, The Netherlands, 2017; pp. 1–30. [Google Scholar]
- Cao, J.; Li, X.M.; Li, X.; Li, H.L.; Meng, L.H.; Wang, B.G. New lactone and isocoumarin derivatives from the marine mangrove-derived endophytic fungus Penicillium coffeae MA-314. Phytochem. Lett. 2019, 32, 1–5. [Google Scholar] [CrossRef]
- Iacovelli, R.; He, T.; Allen, J.L.; Hackl, T.; Haslinger, K. Genome sequencing and molecular networking analysis of the wild fungus Anthostomella pinea reveal its ability to produce a diverse range of secondary metabolites. Fungal Biol. Biotechnol. 2024, 11, 1. [Google Scholar] [CrossRef]

| Sr. No. | Identity | Strain | ITS | LSU |
|---|---|---|---|---|
| 1 | Alanomyces indica | CBS 134264 | HF563622 | HF563623 |
| 2 | Alanomyces manoharacharyi * | NFCCI 5738 | PP669818 | PP669820 |
| 3 | Alanomyces manoharacharyi * | NFCCI 5739 | PP669819 | PP669821 |
| 4 | Alanphillipsia aloeigena | CPC:21286; CBS:136408 | NR_137121 | NG_069179 |
| 5 | Alanphillipsia aloes | CBS 136410 | MH866093 | MH877631 |
| 6 | Aplosporella artocarpi | MFLU 22-0108 | ON823183 | ON834371.1 |
| 7 | Aplosporella chromolaenae | MFLUCC:17-1517 | MT214340 | MT214434 |
| 8 | Aplosporella hesperidica | CBS 208.37 | MH867398 | |
| 9 | Aplosporella macropycnidia | CGMCC 3.17725 | KT343648 | |
| 10 | Aplosporella papilata | CBS 121780 | EU101328 | NG_070359.1 |
| 11 | Aplosporella prunicola | CBS 121167 | OM238151 | KF766315 |
| 12 | Aplosporella thailandica | MFLU 16-0615 | NR_154722.1 | |
| 13 | Bagnisiella examinans | CBS 551.66 | KF766148 | KF766316 |
| 14 | Barriopsis iraniana | IRAN 1448C | NR_137030 | NG_058662 |
| 15 | Barriopsis stevensiana | CBS:174.26 | MH854882.1 | MH866375.1 |
| 16 | Botryobambusa fusicoccum | MFLUCC 11-0143 | JX646792 | JX646809 |
| 17 | Botryosphaeria dolichospermatii | NP1 | MH491970 | MH562323 |
| 18 | Botryosphaeria qingyuanensis | CERC 2946 | KX278000 | MF410042 |
| 19 | Botryosphaeria ramosa | CMW 26167 | NR_151841.1 | KF766333 |
| 20 | Cophinforma atrovirens | CERC 3490 | KX278009 | MF410051 |
| 21 | Cophinforma mamani | CBS 117444 | KF531822 | DQ377855 |
| 22 | Diplodia allocellula | CMW 36468 | JQ239397 | JQ239410 |
| 23 | Diplodia seriata | CBS 112555 | KF766161 | KF766327 |
| 24 | Dothiorella acacicola | CPC 26349 | KX228269 | KX228320 |
| 25 | Dothiorella brevicollis | CMW 36463 | JQ239403 | JQ239416 |
| 26 | Dothiorella viticola | CBS 117010 | AY905558 | KX464344 |
| 27 | Endomelanconiopsis endophytica | CBS 120397 | KF766164 | EU683629 |
| 28 | Endomelanconiopsis freycinetiae | MFLUCC 17-0547 | NR_158434 | MG646948 |
| 29 | Endomelanconiopsis microspora | CBS 353.97 | KF766165 | KF766330 |
| 30 | Eutiarosporella darliae | CBS 118530 | KX464131 | KX464346 |
| 31 | Fusicladium convolvularum | CBS 112706 | AY251082 | EU035428 |
| 32 | Fusicladium oleagineum | CBS 113427 | KF766166 | KF766331 |
| 33 | Guignardia alliacea | MUCC0014 | AB454263 | |
| 34 | Guignardia bidwellii | CBS 111645 | EU683672 | DQ377876 |
| 35 | Guignardia citricarpa | CBS 828.97 | FJ538318 | KF766334 |
| 36 | Kellermania confuse | CBS 131723 | KF766174 | KF766344 |
| 37 | Kellermania pseudoyuccigena | CBS 136446; CPC:20386 | MH866092 | MH877630 |
| 38 | Kellermania yuccigena | CBS 131727 | KF766186 | KF766356 |
| 39 | Lasiodiplodia parva | CBS 456.78 | KF766192 | KF766362 |
| 40 | Lasiodiplodia theobromae | CBS 164.96 | AY640255 | EU673253 |
| 41 | Macrophomina phaseolina | CBS 162.25 | KF531826 | DQ377905 |
| 42 | Macrophomina tecta | BRIP:70781 | MW591684 | |
| 43 | Melanops fagicola | MFLU 19-2862 | MT185519 | MT183482 |
| 44 | Melanops tulasnei | CBS 116805 | FJ824769 | KF766365 |
| 45 | Mucoharknessia cortaderiae | CPC 19974 | KM108374 | KM108401 |
| 46 | Neodeightonia palmicola | MFLUCC 10-0822 | NR_111550 | NG_042534 |
| 47 | Neofusicoccum grevilleae | CPC 16999 | JF951137 | JF951157 |
| 48 | Neofusicoccum kwambonambiense | CBS:123639 | MH863317 | NG_069915 |
| 49 | Neofusicoccum parvum | CMW 9081 | KF766204 | NG_042409 |
| 50 | Neoscytalidium novaehollandiae | CBS 122071 | KF766207 | MH874720 |
| 51 | Phaeobotryon cupressi | CBS 124700 | MH863400 | KX464538 |
| 52 | Phaeobotryon negundinis | MFLUCC 15-0436 | NR_155669 | NG_069332 |
| 53 | Phyllosticta aspidistricola | MUCC0010 | AB454260 | |
| 54 | Phyllosticta capitalensis | CBS 226.77 | FJ538336 | KF766377 |
| 55 | Phyllosticta citribraziliensis | CBS 100098 | OL957175 | NG_069153 |
| 56 | Phyllosticta philoprina | CBS 174.77 | KF766170 | KF766340 |
| 57 | Phyllosticta podocarpi | CBS 111647 | KF766217 | KF766383 |
| 58 | Pileospora piceae | DAOMC251533 | MH144182 | MH144186 |
| 59 | Pileospora piceae | NB-334-4A | MH144181 | MH144184 |
| 60 | Pseudofusicoccum adansoniae | CBS 122055 | KF766220 | KF766386 |
| 61 | Pseudofusicoccum adansoniae | CMW 26147 | KF766220 | KF766386 |
| 62 | Pseudofusicoccum kimberleyense | CBS 122058 | KF766222 | MH874716 |
| 63 | Pseudofusicoccum stromaticum | CBS 117448 | KF766223 | KF766389 |
| 64 | Saccharata hawaiiensis | CBS 111787 | KX464233 | KX464543 |
| 65 | Saccharata kirstenboschensis | CBS 123537 | KF766225 | FJ372409 |
| 66 | Saccharata leucospermi | CBS:122694 | EU552129 | |
| 67 | Saccharata proteae | CBS 115498 | KX464236 | KX464546 |
| 68 | Septorioides pini-thunbergii | CBS 473.91 | MH862264 | MH873946 |
| 69 | Tiarosporella madreeya | CBS 532.76 | KM108376 | DQ377940 |
| 70 | Tiarosporella tritici | CBS 118719 | KC769961 | DQ377941 |
| 71 | Umthunziomyces hagahagensis | CPC 29917 | KY173472 | KY173561 |
| Sr. No. | Organism | Strain | GenBank Assembly Accession |
|---|---|---|---|
| 1 | Aplosporella prunicola | CBS 121167 | GCA_010093885.1 |
| 2 | Botryosphaeria agaves | FJII-L1-SW-P2 | GCA_022813555.1 |
| 3 | Botryosphaeria dothidea | sdau11-99 | GCA_011503125.2 |
| 4 | Botryosphaeria dothidea | CK28 | GCA_021650725.1 |
| 5 | Botryosphaeria dothidea | GS.01s2 | GCA_029169245.1 |
| 6 | Botryosphaeria kuwatsukai | KE8637 | GCA_023084525.1 |
| 7 | Botryosphaeria kuwatsukai | PG2 | GCA_004016305.1 |
| 8 | Diplodia corticola | CBS 112549 | GCA_001883845.1 |
| 9 | Diplodia intermedia | M45-28 | GCA_021495925.1 |
| 10 | Diplodia mutila | CBS 112553 | GCA_022560015.1 |
| 11 | Diplodia mutila | KE84208 | GCA_023089405.1 |
| 12 | Diplodia sapinea | KE8364 | GCA_023087385.1 |
| 13 | Diplodia sapinea | KE8391 | GCA_023087305.1 |
| 14 | Diplodia sapinea | KE8634 | GCA_023085605.1 |
| 15 | Diplodia scrobiculata | CMW30223 | GCA_001455585.1 |
| 16 | Diplodia seriata | FDS-637 | GCA_021436955.2 |
| 17 | Diplodia seriata | M28-159 | GCA_021436965.1 |
| 18 | Diplodia seriata | F98.1 | GCA_001975905.1 |
| 19 | Dothiorella sarmentorum | KEdek | GCA_023082095.1 |
| 20 | Dothiorella sarmentorum | KE84560 | GCA_023088305.1 |
| 21 | Lasiodiplodia citricola | KE87127 | GCA_023089105.1 |
| 22 | Lasiodiplodia gonubiensis | CBS 115812 | GCA_009829795.1 |
| 23 | Lasiodiplodia iranensis | CCTCC M2017288 | GCA_030270915.1 |
| 24 | Lasiodiplodia mahajangana | VT137 | GCA_029590625.1 |
| 25 | Lasiodiplodia pseudotheobromae | WHSB4P03s | GCA_029169085.1 |
| 26 | Lasiodiplodia pseudotheobromae | CBS 116459 | GCA_009829805.1 |
| 27 | Lasiodiplodia pseudotheobromae | BaA | GCA_029931825.1 |
| 28 | Lasiodiplodia theobromae | AM2As | GCA_012971845.1 |
| 29 | Lasiodiplodia theobromae | CBS 164.96 | GCA_009829825.1 |
| 30 | Lasiodiplodia theobromae | A20-4 | GCA_018153875.1 |
| 31 | Macrophomina phaseolina | mp053 | GCA_020875535.1 |
| 32 | Macrophomina phaseolina | CBS 205.47 | GCA_022204945.1 |
| 33 | Macrophomina phaseolina | mp102 | GCA_020875235.1 |
| 34 | Macrophomina phaseolina | Al-1 | GCA_008729065.1 |
| 35 | Macrophomina pseudophaseolina | WAC 2767 | GCA_022204955.1 |
| 36 | Macrophomina tecta | BRIP 70781 | GCA_024180945.1 |
| 37 | Neofusicoccum cordaticola | CBS 123638 | GCA_009830905.1 |
| 38 | Neofusicoccum cordaticola | CBS 123634 | GCA_009829355.1 |
| 39 | Neofusicoccum kwambonambiense | CBS 123642 | GCA_009829855.1 |
| 40 | Neofusicoccum kwambonambiense | CBS 123639 | GCA_009829845.1 |
| 41 | Neofusicoccum laricinum | HLJ-QQHE-4 | GCA_029906385.1 |
| 42 | Neofusicoccum laricinum | MAFF 410183 | GCA_022609205.1 |
| 43 | Neofusicoccum parvum | DUCC19944 | GCA_020912385.1 |
| 44 | Neofusicoccum parvum | GX.1 | GCA_029169195.1 |
| 45 | Neofusicoccum parvum | SCCDJF01s | GCA_029169155.1 |
| 46 | Neofusicoccum parvum | AH.3.1.01s | GCA_029169165.1 |
| 47 | Neofusicoccum parvum | NSSI1 | GCA_030270365.1 |
| 48 | Neofusicoccum ribis | M1-105 | GCA_021436925.1 |
| 49 | Neofusicoccum ribis | CBS 121.26 | GCA_009829435.1 |
| 50 | Neofusicoccum ribis | CBS 115475 | GCA_009829445.1 |
| 51 | Neofusicoccum umdonicola | CBS 123644 | GCA_009829365.1 |
| 52 | Neoscytalidium dimidiatum | GCA_900092665.1 | |
| 53 | Scolecobasidium constrictum | UM 578 | GCA_000611715.1 |
| 54 | Verruconis gallopava | CBS 43764 | GCA_000836295.1 |
| Mass-to-Charge Ratio (m/z) | Signal-to-Noise Ratio (S/N) | Relative Intensity | Intensity | Area |
|---|---|---|---|---|
| 6159.890 | 6 | 1017 | 407 | 3152 |
| 6399.786 | 6 | 945 | 343 | 4008 |
| 6736.835 | 4 | 732 | 212 | 2959 |
| 6783.503 | 5 | 631 | 315 | 3820 |
| 6850.893 | 7 | 1115 | 384 | 4403 |
| 6863.095 | 5 | 508 | 278 | 4693 |
| 6885.070 | 4 | 1119 | 225 | 1951 |
| 13,628.300 | 3 | 2080 | 78.4 | 940 |
| 13,647.798 | 4 | 1819 | 93.8 | 1140 |
| 13,666.029 | 6 | 1736 | 137 | 2164 |
| 13,690.444 | 9 | 987 | 211 | 3387 |
| 13,703.697 | 11 | 1893 | 248 | 4071 |
| 13,725.278 | 10 | 1732 | 232 | 3510 |
| 13,744.521 | 7 | 1317 | 154 | 2397 |
| 13,763.051 | 6 | 2049 | 127 | 1642 |
| 13,781.868 | 5 | 1823 | 105 | 1228 |
| 13,799.257 | 5 | 942 | 115 | 2326 |
| 13,816.129 | 5 | 2717 | 111 | 1086 |
| 13,828.615 | 5 | 1979 | 109 | 1272 |
| 13,844.702 | 4 | 1338 | 96.2 | 1390 |
| 13,867.006 | 3 | 1868 | 78.7 | 969 |
| 13,876.685 | 3 | 1644 | 74.6 | 837 |
| Assembly | MaSurCa 4.0.5 | Megahit v1.2.9 | Spades v3.15.4 |
|---|---|---|---|
| Contigs (≥1000 bp) | 1756 | 946 | 264 |
| Contigs (≥5000 bp) | 1118 | 508 | 210 |
| Contigs (≥10,000 bp) | 850 | 383 | 189 |
| Contigs (≥25,000 bp) | 465 | 254 | 157 |
| Contigs (≥50,000 bp) | 189 | 175 | 130 |
| Largest contig | 188,634 | 705,157 | 1,303,379 |
| Total length MB | 35.11 | 35.11 | 35.55 |
| GC (%) | 50.17 | 50.20 | 50.01 |
| N50 | 44,101 | 179,965 | 408,258 |
| N75 | 22,880 | 70,317 | 184,668 |
| L50 | 238 | 62 | 28 |
| L75 | 509 | 140 | 60 |
| Region | Type | From | To | Most Similar Known Cluster | Similarity |
|---|---|---|---|---|---|
| 1.1 | terpene | 524,885 | 549,944 | Unknown | |
| 1.2 | T1PKS | 609,421 | 655,601 | Unknown | |
| 3.1 | T1PKS | 364,877 | 412,826 | Unknown | |
| 3.2 | beta lactone | 788,545 | 819,430 | Unknown | |
| 4.1 | terpene | 542,906 | 564,883 | Unknown | |
| 6.1 | T1PKS | 327,748 | 374,361 | 1,3,6,8-tetrahydroxynaphthalene | 100% |
| 9.1 | NRPS | 1 | 37,540 | Unknown | |
| 11.1 | NRPS | 125,072 | 182,954 | Unknown | |
| 13.1 | NRPS-like | 475,006 | 519,581 | Unknown | |
| 14.1 | terpene | 383,448 | 404,640 | aspterric acid | 100% |
| 17.1 | NRPS-like | 224,629 | 266,991 | Unknown | |
| 21.1 | fungal-RiPP-like | 102,085 | 163,886 | Unknown | |
| 23.1 | NRPS | 7288 | 59,760 | metachelin C/metachelin A/metachelin A-CE/metachelin B/dimerumic acid 11-mannoside/dimerumic acid | 25% |
| 27.1 | NRPS | 267,137 | 313,758 | chaetocin | 26% |
| 31.1 | T1PKS, indole | 334,087 | 379,753 | viridicatumtoxin/previridicatumtoxin/5-hydroxyanthrotainin/8-O-desmethylanthrotainin | 27% |
| 37.1 | NRPS-like | 270,391 | 314,084 | Unknown | |
| 52.1 | T1PKS, NRPS | 119,781 | 174,132 | phomasetin | 28% |
| 59.1 | NRPS-like | 15,287 | 58,424 | Unknown | |
| 65.1 | T1PKS | 6392 | 51,803 | (-)-Mellein | 100% |
| 67.1 | T1PKS | 52,155 | 97,544 | cryptosporioptide B/cryptosporioptide A/cryptosporioptide C | 15% |
| 78.1 | NRPS | 52,473 | 99,306 | metachelin C/metachelin A/metachelin A-CE/metachelin B/dimerumic acid 11-mannoside/dimerumic acid | 25% |
| 79.1 | NRPS-like | 42,248 | 85,160 | Biotin | 66% |
| 92.1 | NRPS | 1 | 66,959 | Unknown | |
| 94.1 | NRPS-like | 58,224 | 93,374 | Unknown | |
| 96.1 | NRPS | 227 | 69,345 | Unknown | |
| 141.1 | T1PKS | 1 | 36,822 | Patulin | 26% |
| Compound Name | Class |
|---|---|
| Aspartate semialdehyde | Aldehydes: Amino Acid Metabolite |
| N-Acetyl-D-leucine | Amino Acid Derivative |
| PG(20:0/25:0) | Lipids: Phosphatidylglycerol Lipid |
| Dihydroaltersolanol and Dihydroaltersolanol C | Secondary Metabolites: tetrahydroanthraquinone |
| Propericiazine (oxide) | Secondary metabolites: Phenothiazine |
| 2-trans,6-trans-farnesyl diphosphate | Lipids: Terpene Precursor |
| Mooreamide A | Peptide |
| 5-Dihydroergosterol | Lipids: Sterol |
| Mycocerosic acid (C28) | Lipids: Fatty Acid |
| Aspergiolide B | Secondary metabolites: Anthraquinones |
| Alpha-Carotene | Lipids: Carotenoid |
| PE-NMe2(10:0/12:0) | Lipids: Phospholipid |
| DG(15:0/20:0/0:0) | Lipids: Diacylglycerol |
| Flavocristamide A | Peptide |
| N-(24-Hydroxytetracosanoyl)phytosphingosine | Lipids: Sphingolipid |
| 5-Sulfosalicylic acid | Organic Acid |
| Penicoffrazin B/C | Hydroxybenzoic acid derivatives: Isocoumarins |
| Feruloylcholine | Phenolic Compound |
| 7,10-dihydroxydeacetyldihydrobotrydial-1(10)-ene | Botrydial sesquiterpenoids |
| Gregatin G1 and Gregatin G2 | Secondary metabolites: Polyketide |
| coscinolactam D | Secondary metabolites: Sesterterpenoids |
| Photopiperazine A | Cyclodipeptides: Diketopiperazines |
| 17-hydroxy-glaciapyrrole B | Secondary metabolites: Pyrrolosesquiterpenes |
| clarhamnoside or LLG-1 | Glycoside |
| GlcNAcbeta1-3Galbeta1-4(Fucalpha1-3)GlcNAcbeta1… | Carbohydrates: Oligosaccharide |
| Pregnane-3,6,20-triol, (3alpha,5beta,6alpha,20S) | Steroid |
| Chaetochiversin A | Peptide |
| aplyviolene | Secondary metabolites: Diterpene |
| Thiomuracin E | Thiopeptides: Antibiotic |
| Cer(d22:0/39:0) | Lipids: Ceramide |
| GlcNAc (N-acetylglucosamine) | Carbohydrates: Monosaccharide |
| CL(1′-[16:0/18:0],3′-[18:2(9Z,12Z)/20:4(5Z,8Z,1… | Lipids: Cardiolipin |
| Anvilone B | Secondary metabolites: Sesterterpenoids |
| Oscillatoxin b1/b2 | Toxin |
| DG(16:1(9Z)/18:0/0:0) | Lipids: Diacylglycerol |
| TG(10:0/10:0/14:1(9Z)) | Lipids: Triglyceride |
| DG(20:0/20:1(13Z)/0:0) | Lipids: Diacylglycerol |
| Maltulose | Carbohydrates: Disaccharide |
| Nagelamide R/Z | Peptide |
| Sarcohydroquinone sulfate B | Secondary metabolites: Disulfate heptaprenyl hydroquinone |
Disclaimer/Publisher’s Note: The statements, opinions and data contained in all publications are solely those of the individual author(s) and contributor(s) and not of MDPI and/or the editor(s). MDPI and/or the editor(s) disclaim responsibility for any injury to people or property resulting from any ideas, methods, instructions or products referred to in the content. |
© 2024 by the authors. Licensee MDPI, Basel, Switzerland. This article is an open access article distributed under the terms and conditions of the Creative Commons Attribution (CC BY) license (https://creativecommons.org/licenses/by/4.0/).
Share and Cite
Rana, S.; Singh, S.K. Discovery of Alanomyces manoharacharyi: A Novel Fungus Identified Using Genome Sequencing and Metabolomic Analysis. J. Fungi 2024, 10, 791. https://doi.org/10.3390/jof10110791
Rana S, Singh SK. Discovery of Alanomyces manoharacharyi: A Novel Fungus Identified Using Genome Sequencing and Metabolomic Analysis. Journal of Fungi. 2024; 10(11):791. https://doi.org/10.3390/jof10110791
Chicago/Turabian StyleRana, Shiwali, and Sanjay K. Singh. 2024. "Discovery of Alanomyces manoharacharyi: A Novel Fungus Identified Using Genome Sequencing and Metabolomic Analysis" Journal of Fungi 10, no. 11: 791. https://doi.org/10.3390/jof10110791
APA StyleRana, S., & Singh, S. K. (2024). Discovery of Alanomyces manoharacharyi: A Novel Fungus Identified Using Genome Sequencing and Metabolomic Analysis. Journal of Fungi, 10(11), 791. https://doi.org/10.3390/jof10110791

